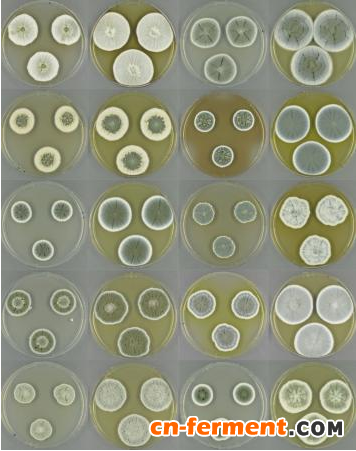

真菌或许能够成为抵御细菌和其他微生物引起的感染提供新的药物宝库。这是来自瑞典哥德堡查尔默斯技术大学的科学家们得出的结论。他们对数种真菌的基因组进行扫描并确认了 1,000 多种合成生物活性物质的路径。研究小组认为,这一研究结果可能是解决全球抗生素耐药性问题的重要一步。
研究人员在《自然微生物学》杂志上发表的一篇论文中报道了他们的研究成果。
我们对真菌的了解比细菌少得多
研究人员指出,我们在自然界中寻找新型抗生素的尝试主要都集中在细菌,因为它们比真菌更容易研究,我们对真菌了解得太少。
然而,他们指出,真菌(很像细菌)也会生成生物活性物质来抵御对手。
因此,研究小组决定使用之前原来研究细菌的基因组测序工具对真菌及其产生生物活性物质的潜力进行分析。
1,000 多种合成生物活性物质的路径
从 24 个不同种类青霉菌的基因组测序数据中,研究小组发现了 1,000 多种合成生物活性物质的路径——特定分子反应模式和事件——可用于生产具有药用潜力的多种生物活性物质。
研究人员能够预测其中 90 种路径能够生成哪些化合物——包括产生抗生素,他们称之为 yanuthones。
经进一步研究,他们发现了一个以前未见记载的 yanuthone——它是由一类青霉素生成,之前并不知道可生成 yanuthones。
因此,作者认为,他们的研究结果表明真菌不仅可能为新型抗生素提供一个巨大的潜在来源,或许还打开了一个旧药翻新——或许更为有效——的来源。他们得出以下结论:
“这项研究是对青霉菌基因组多样性首次进行的广属分析,突出了这些物种作为一种新型抗生素及其他药物来源的潜力。





















































